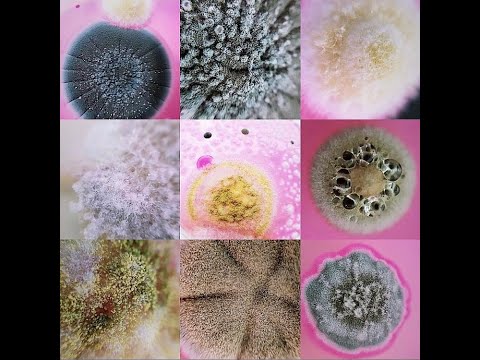

Contagem de bolores e leveduras
4.99k views2 WordsCopy TextShare

Elisângela Serenato Madalozzo
No vídeo é demonstrada a técnica para a contagem de bolores e leveduras em alimentos.
Video Transcript:
No transcript available.
Related Videos
No transcript available.